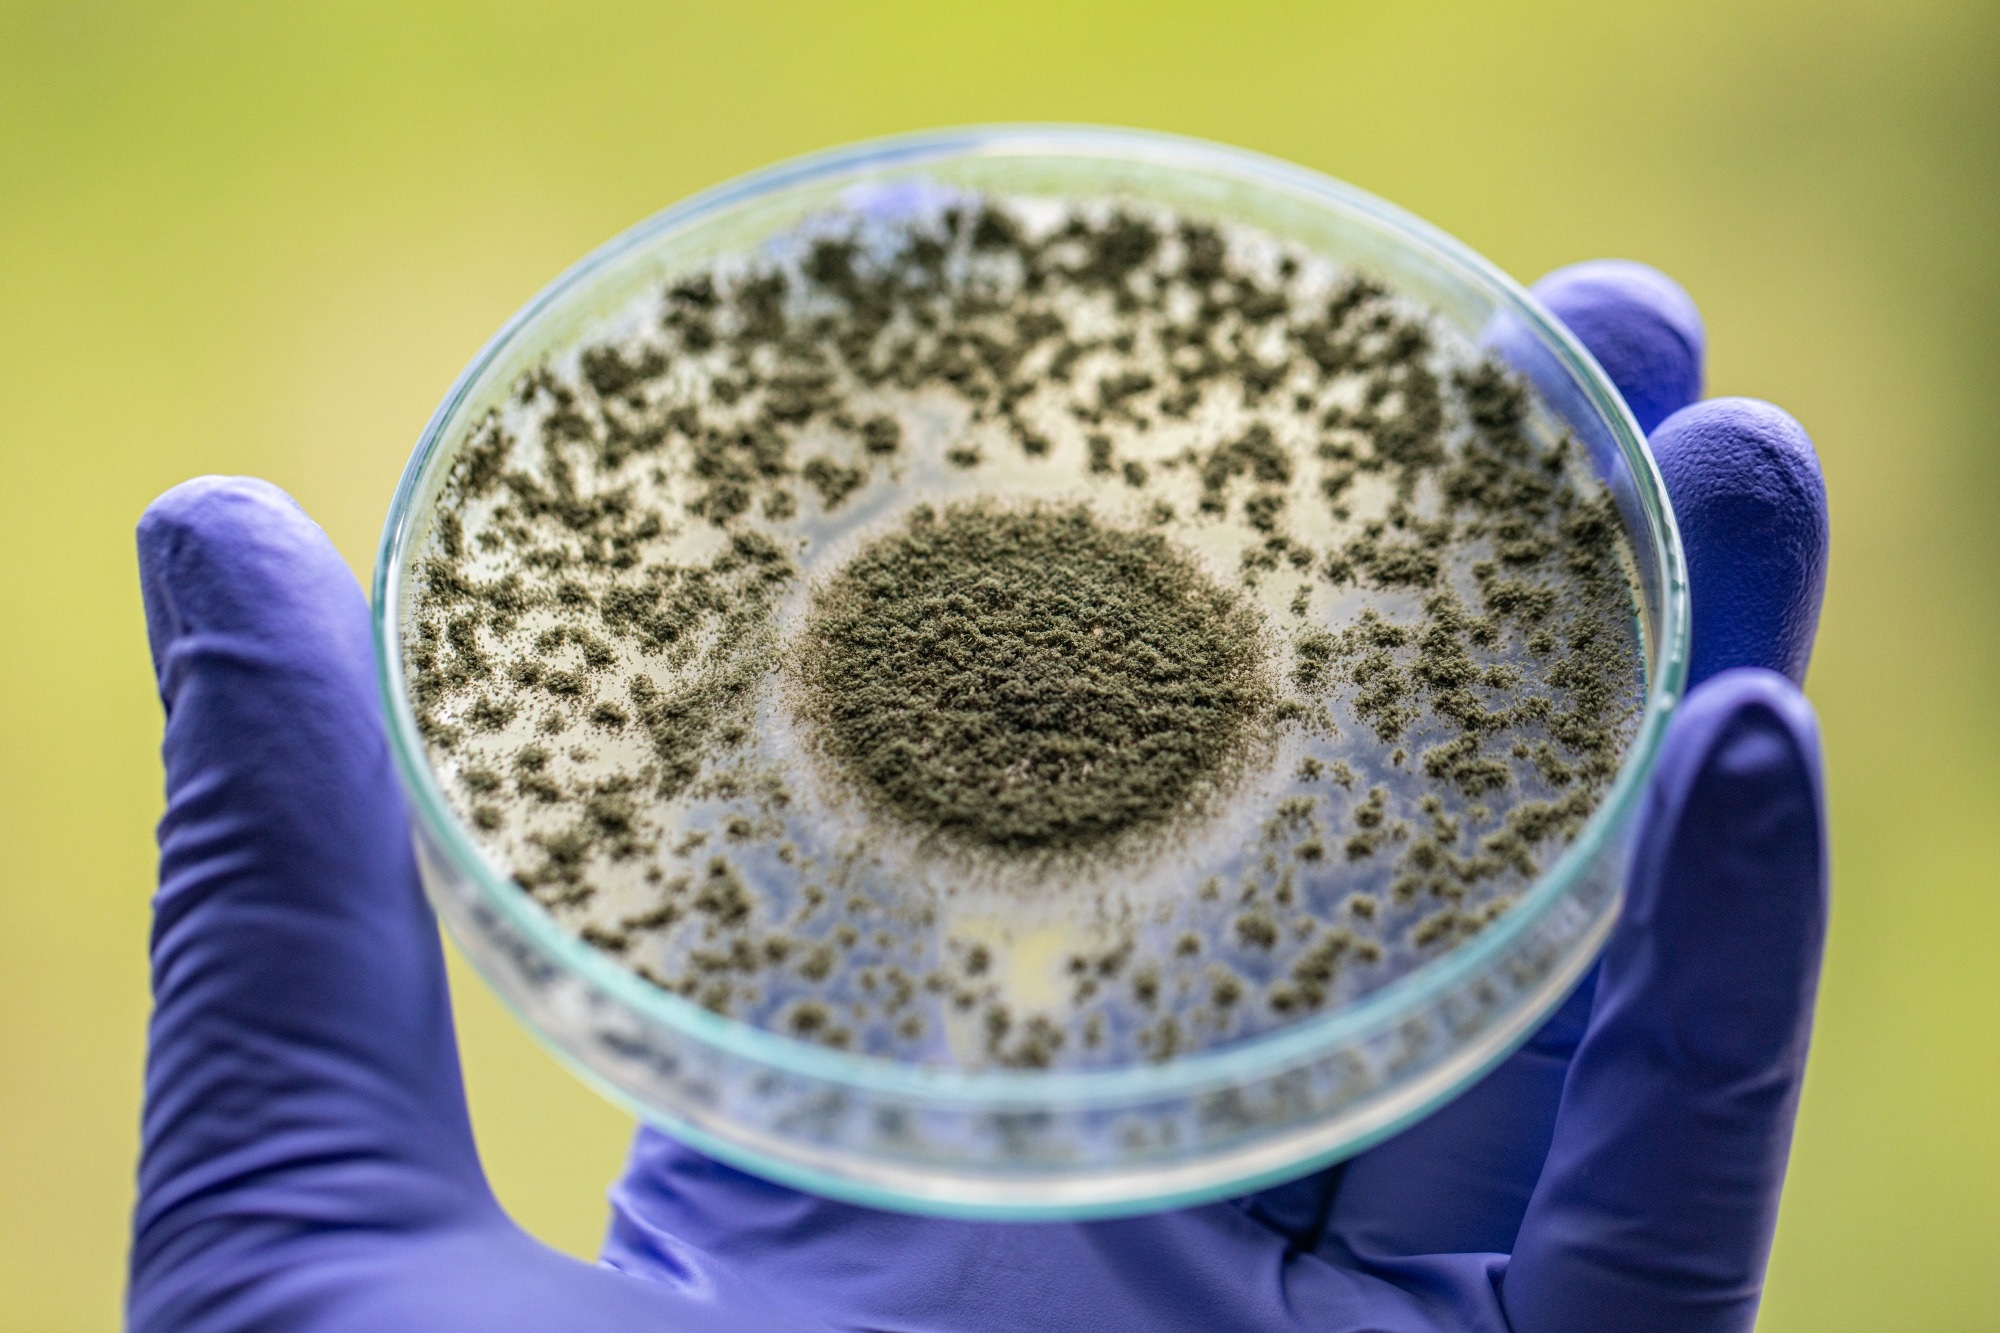

Introduction
What is Aspergillosis?
Types of Aspergillosis
Populations at Risk
Re-Emergence and Recent Trends
Diagnostic and Treatment Challenges
Public Health Implications
Conclusion
References
Further Reading
With surging antifungal resistance and a rise in severe infections following the COVID-19 pandemic, aspergillosis has re-emerged as a critical threat to vulnerable patients worldwide, underscoring the need for rapid diagnosis, new treatments, and stronger public health surveillance.
 Image Credit: Kateryna Kon / Shutterstock.com
Image Credit: Kateryna Kon / Shutterstock.com
Introduction
Aspergillosis is a fungal infection caused by Aspergillus species, a fungus commonly found in soil, decaying vegetation, and indoor environments. While harmless to most people, aspergillosis can cause serious illness in individuals with weakened immune systems, lung diseases, or allergies.
In recent years, the global rise in immunocompromised populations and antifungal resistance has made aspergillosis a growing concern. The potential of this pathogen to cause outbreaks in healthcare settings further underscores its relevance as an emerging public health threat that requires heightened awareness and surveillance.1
This article covers aspergillosis, focusing on its rise following the coronavirus disease 2019 (COVID-19) pandemic, antifungal resistance, diagnostic challenges, and public health implications.
What is Aspergillosis?
Aspergillosis refers to a spectrum of diseases caused by inhalation of spores from Aspergillus mold, most commonly Aspergillus fumigatus. Aspergillus produces small, airborne conidia that are typically 2-3 micrometers (µm) in diameter, allowing these pathogens to reach the pulmonary alveoli and either be cleared or trigger disease, depending on the host’s immune status and lung condition.2
Transmission occurs through the inhalation of spores that are widespread in the environment, particularly in decomposing organic matter such as compost, leaves, and soil. Aspergillosis is not transmitted between individuals; rather, outbreaks often occur in healthcare settings with high fungal load.
Types of Aspergillosis
Understanding the distinct forms of aspergillosis is essential for early diagnosis and targeted treatment.2 The most common forms of aspergillosis include allergic bronchopulmonary aspergillosis (ABPA), chronic pulmonary aspergillosis, and invasive aspergillosis.
ABPA is an exaggerated immune response that primarily occurs in individuals with asthma or cystic fibrosis. This form of aspergillosis is characterized by airway inflammation, mucus plugging, and bronchiectasis.
Chronic pulmonary aspergillosis develops over a period of several months or years in people with underlying lung disease. Common symptoms associated with chronic pulmonary aspergillosis include cough, weight loss, and fatigue.
Invasive aspergillosis is the most severe form of aspergillosis. Often occurring in immunocompromised patients, invasive aspergillosis involves tissue invasion and can rapidly disseminate beyond the lungs.2
Image Credit: Sinhyu Photographer / Shutterstock.com
Image Credit: Sinhyu Photographer / Shutterstock.com
Populations at Risk
Immunocompromised individuals, such as cancer patients undergoing chemotherapy, organ transplant recipients on immunosuppressive therapy, as well as those with acquired immunodeficiency syndrome (AIDS), are particularly vulnerable to aspergillosis due to their weakened immune systems. People with chronic lung conditions, such as asthma and chronic obstructive pulmonary disease (COPD), are also at a greater risk of contracting aspergillosis, as their damaged lung tissues provide a suitable environment for Aspergillus species to grow and invade.3
Even individuals without traditional risk factors have developed invasive pulmonary aspergillosis following severe viral infections like COVID-19. In fact, recent studies indicate that patients diagnosed with severe COVID-19, especially those requiring mechanical ventilation or experiencing acute respiratory distress syndrome, frequently experience co-infections with Aspergillus fumigatus. Aspergillus fumigatus co-infection with COVID-19 is associated with high mortality and often occurs in patients who are not classically immunocompromised.3
Elevated levels of interleukin-6 (IL-6) and interleukin-10 (IL-10) after COVID-19 may suppress immune function, thereby increasing susceptibility to fungal infections. As a result, aspergillosis has become a growing concern for patients with known immune suppression, as well as those recovering from serious viral illnesses. Greater awareness and early diagnostic testing are crucial for detecting fungal co-infections in all critically ill patients, regardless of their previous health status.3
Re-Emergence and Recent Trends
The recent rise in fungal infections, particularly following the COVID-19 pandemic, is attributed to the widespread use of corticosteroids and weakened immune responses in patients recovering from severe viral illnesses. Opportunistic fungal pathogens, such as Candida auris and Aspergillus fumigatus, have been responsible for invasive infections, even in previously healthy individuals. Notably, COVID-19-associated pulmonary aspergillosis and mucormycosis have caused outbreaks, particularly in India.4
Compounding this threat is growing resistance to antifungal medications, which is especially concerning given the limited number of antifungal drug classes that are currently available. For example, azole-resistant strains of Aspergillus fumigatus are emerging globally, partly due to the use of environmental fungicides in agriculture.4
Geographic shifts in fungal disease patterns are also evident. Diseases like coccidioidomycosis or Valley fever, which were previously restricted to parts of the southwestern United States, are now spreading to new areas. Researchers project that climate conditions, such as alternating periods of drought and rainfall, could expand the endemic range of these pathogens and increase annual case numbers by 50% by the year 2100.4
Rising temperatures, increased humidity, and extreme weather events such as hurricanes, wildfires, and floods have created favorable conditions for fungi to thrive and spread. Exposure to wildfire smoke and flood-related mold contamination has also been linked to spikes in systemic fungal infections.4,7

Immunosuppressive treatments, drug resistance, shifting ecologies, and environmental disruption underscore the urgent need for stronger fungal surveillance, research, and mitigation strategies to manage the growing global threat of invasive fungal diseases.4
'Aspergillus' Fungi Threat Grows, Scientists Say 'Millions Are At Risk' | Climate Tracker
Diagnostic and Treatment Challenges
Diagnosing and treating invasive aspergillosis is complex and often delayed due to nonspecific symptoms and limitations in current diagnostic methods. Accurate detection typically relies on advanced tools, including high-resolution computed tomography (CT) scans, fungal cultures, and laboratory tests such as galactomannan assays, beta-glucan testing, and polymerase chain reaction (PCR). Despite these advancements, late-stage detection is common, which increases the risk of poor treatment outcomes.5
The widespread use of fluconazole, which does not act against molds, has led to an increase in colonization by resistant fungal species. Newer broad-spectrum antifungals such as voriconazole and posaconazole are more effective against aspergillosis; however, cases of breakthrough fungal infections, particularly by other species, have been reported, even during treatment.5
Voriconazole is the current standard treatment for aspergillosis and has been associated with improved survival rates as compared to amphotericin B treatment. Nevertheless, voriconazole can lead to unwanted side effects both directly and as a result of its interactions with other medications.
Echinocandins, such as micafungin and caspofungin, offer options for patients who cannot tolerate standard treatments; however, their high cost and requirement for intravenous administration limit their widespread application. Ongoing studies are investigating new drugs and diagnostic tools to support earlier and more targeted interventions.5
Public Health Implications
The rise of antimicrobial resistance and healthcare-associated infections has placed a significant burden on healthcare systems, especially in low- and middle-income countries. Intensive care units (ICUs) are particularly affected, with infections such as ventilator-associated pneumonia and catheter-related bloodstream infections leading to prolonged hospital stays, increased mortality, and greater healthcare costs. During outbreaks, the limited capacity of ICUs becomes a critical challenge, thus emphasizing the importance of preventive strategies.6
In resource-poor settings, infection prevention and control programs, as well as antimicrobial stewardship initiatives, face significant barriers to success. Some of these challenges include a shortage of trained professionals, a lack of diagnostic tools, and insufficient access to essential supplies such as personal protective equipment, disinfectants, and isolation rooms. Furthermore, many hospitals lack the necessary infrastructure to support surveillance or timely diagnosis, further complicating response efforts.6
Many surveillance systems are either weak or absent, with most data obtained from a few hospitals and lacking national representation, all of which are factors that limit the ability to monitor trends in antimicrobial resistance. The widespread availability of antibiotics without prescriptions also accelerates the emergence of resistant strains.6
Public health responses must include increased investment in surveillance networks, mandatory stewardship programs, and integrated One Health strategies. Ensuring diagnostic access, standardizing protocols, and improving ICU preparedness are crucial steps to protect vulnerable populations and reduce global health risks.6
Conclusions
Aspergillosis has re-emerged as a serious global health concern due to rising immunosuppression, antifungal resistance, and changing environmental conditions. Early detection and timely treatment are essential to reduce mortality, particularly in critically ill and immunocompromised individuals.
Persistent challenges to overcome this public health threat include delayed diagnosis, limited treatment options, and insufficient capacity in intensive care units (ICUs), all of which require urgent action. Public health systems must focus on increasing awareness, improving surveillance, and advancing diagnostic and treatment tools. Strengthening antifungal stewardship and infection control is crucial. Continued research funding and international collaboration are needed to protect vulnerable populations and manage this growing threat.
References
- Mousavi, B., Hedayati, M. T., Hedayati, N., Ilkit, M., & Syedmousavi, S. (2016). Aspergillus species in indoor environments and their possible occupational and public health hazards. Current medical mycology, 2(1), 36. DOI: 10.18869/acadpub.cmm.2.1.36, https://pubmed.ncbi.nlm.nih.gov/28681011/
- SISODIA, J., & Bajaj, T. (2023). Allergic bronchopulmonary aspergillosis. In StatPearls [Internet]. StatPearls Publishing. https://www.ncbi.nlm.nih.gov/books/NBK542329/
- Lai, C. C., & Yu, W. L. (2021). COVID-19 associated with pulmonary aspergillosis: A literature review. Journal of Microbiology, Immunology and Infection, 54(1), 46-53. DOI: 10.1016/j.jmii.2020.09.004, https://www.sciencedirect.com/science/article/pii/S1684118220302383
- Konkel Neabore, L. (2024). Wake-up call: rapid increase in human fungal diseases under climate change. DOI: 10.1289/EHP14722, https://ehp.niehs.nih.gov/doi/full/10.1289/EHP14722
- Baddley, J. W., & Apewokin, S. (2008). Prevention of invasive aspergillosis in high-risk patients: Universal versus preemptive, targeted treatment. Current fungal infection reports, 2(2), 61-68. DOI:10.1007/s12281-008-0010-6, https://link.springer.com/article/10.1007/s12281-008-0010-6
- Abbas, S. (2024). The challenges of implementing infection prevention and antimicrobial stewardship programs in resource-constrained settings. Antimicrobial Stewardship & Healthcare Epidemiology, 4(1), e45. DOI:10.1017/ash.2024.35, https://www.cambridge.org/core/journals/antimicrobial-stewardship-and-healthcare-epidemiology/article/challenges-of-implementing-infection-prevention-and-antimicrobial-stewardship-programs-in-resourceconstrained-settings/BE2C4293F06F6B03834972F5149050A5
- Norman van Rhijn, Christopher Uzzell, Jennifer Shelton et al. Climate change-driven geographical shifts in Aspergillus species habitats and their implications for plant and human health. Research Square (2025). DOI: 10.21203/rs.3.rs-6545782/v1, https://www.researchsquare.com/article/rs-6545782/v1
Further Reading
Last Updated: Jun 5, 2025